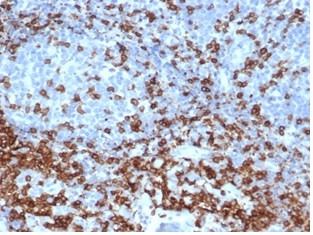
CD3e (T-Cell Marker) Antibody in Immunohistochemistry (Paraffin) (IHC (P))

Search
NeoBiotechnologies
CD3e (T-Cell Marker) Recombinant Rabbit Monoclonal Antibody (C3e/4652R)
{{$productOrderCtrl.translations['antibody.pdp.commerceCard.promotion.promotions']}}
{{$productOrderCtrl.translations['antibody.pdp.commerceCard.promotion.viewpromo']}}
{{$productOrderCtrl.translations['antibody.pdp.commerceCard.promotion.promocode']}}: {{promo.promoCode}} {{promo.promoTitle}} {{promo.promoDescription}}. {{$productOrderCtrl.translations['antibody.pdp.commerceCard.promotion.learnmore']}}
产品信息
916-RBM22-P1
种属反应
宿主/亚型
Expression System
分类
类型
克隆号
抗原
偶联物
形式
浓度
规格
纯化类型
保存液
内含物
保存条件
运输条件
产品详细信息
Antibody is stable for 24 months.
Positive Control: Human peripheral blood. Jurkat cells. Tonsil or lymph node. Cellular Localization: Cell surface. Cytoplasm.
Specificity Comments: Recognizes the epsilon-chain of CD3, which consists of five different polypeptide chains (designated as gamma, delta, epsilon, zeta, and eta) with MW ranging from 16-28kDa. The CD3 complex is closely associated at the lymphocyte cell surface with the T cell antigen receptor (TCR). Reportedly, CD3 complex is involved in signal transduction to the T cell interior following antigen recognition. The CD3 antigen is first detectable in early thymocytes and probably represents one of the earliest signs of commitment to the T cell lineage. In cortical thymocytes, CD3 is predominantly intra-cytoplasmic. However, in medullary thymocytes, it appears on the T cell surface. CD3 antigen is a highly specific marker for T cells, and is present in majority of T cell neoplasms.
Does not react with Cat or Dog
靶标信息
The CD3 complex, composed of gamma, delta, epsilon, and zeta subunits, is essential for the assembly, trafficking, and surface expression of the T cell receptor (TCR) complex. These subunits are structurally related members of the immunoglobulin superfamily and are encoded by closely linked genes on human chromosome 11. CD3 is expressed by thymocytes in a developmentally regulated manner and by all mature T cells, but not on B or NK cells. The CD3 subunits play a crucial role in transducing antigen-recognition signals into the cytoplasm of T cells. The cytoplasmic tails of CD3 subunits contain a double tyrosine-based motif that associates with cytoplasmic signal transduction molecules, mediating T cell activation through the TCR. Crosslinking of the TCR initiates intracellular biochemical pathways that result in cellular activation, proliferation, and potentially growth arrest and cell survival. CD3 is present on 68-82% of normal peripheral blood lymphocytes, 65-85% of thymocytes, and Purkinje cells in the cerebellum. Decreased percentages of T lymphocytes may be observed in some autoimmune diseases. Defects in the CD3 gene are associated with CD3 immunodeficiency, highlighting its importance in immune function and regulation.
仅用于科研。不用于诊断过程。未经明确授权不得转售。
篇参考文献 (0)
生物信息学
蛋白别名: CD247; CD247 antigen, zeta subunit; CD3 antigen, delta subunit; CD3 delta; CD3 TCR complex; CD3-epsilon; CD3d; CD3d antigen, delta polypeptide (TiT3 complex); CD3d molecule, delta (CD3-TCR complex); CD3e; CD3e antigen, epsilon polypeptide (TiT3 complex); CD3e molecule, epsilon (CD3-TCR complex); CD3g; CD3g antigen, gamma polypeptide (TiT3 complex); CD3g molecule, epsilon (CD3-TCR complex); CD3g molecule, gamma (CD3-TCR complex); CD3Z antigen, zeta polypeptide (TiT3 complex); CD3zeta chain; component of the TCR/CD3 complex; FLJ18683; Leu-4; OKT3, delta chain; T cell antigen receptor complex epsilon subunit of T3; T-cell antigen receptor complex, epsilon subunit of T3; T-cell antigen receptor complex, gamma subunit of T3; T-cell antigen receptor complex, zeta subunit of CD3; T-cell receptor T3 delta chain; T-cell receptor T3 gamma chain; T-cell receptor T3 zeta chain; T-cell surface antigen T3/Leu-4 epsilon chain; T-cell surface glycoprotein CD3 delta chain; T-cell surface glycoprotein CD3 epsilon chain; T-cell surface glycoprotein CD3 gamma chain; T-cell surface glycoprotein CD3 zeta chain; T3/TCR complex; TCR zeta; TCR zeta chain; tissue factor-targeting CAR1 dimer; tissue factor-targeting CAR1 monomer; unnamed protein product
基因别名: CD247; CD3-DELTA; CD3-GAMMA; CD3-ZETA; CD3D; CD3DELTA; CD3E; CD3epsilon; CD3G; CD3GAMMA; CD3H; CD3Q; CD3Z; CD3ZETA; IMD17; IMD18; IMD19; IMD25; T3D; T3E; T3G; T3Z; TCRE; TCRZ
UniProt ID: (Human) P20963, (Human) P04234, (Human) P07766, (Human) P09693
Entrez Gene ID: (Human) 919, (Human) 915, (Human) 916, (Human) 917